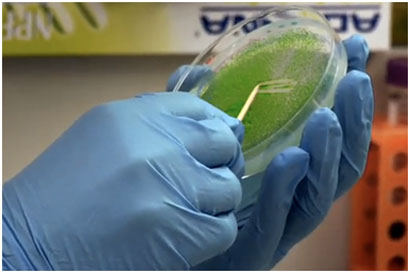

La compagine di Ambios Srl ha
affrontato dalla sua nascita le
problematiche biologiche applicate
ai materiali innovativi, ai processi
di analisi e bonifica di siti
inquinati e non ultimo al settore
della produzione di energia da fonti
rinnovabili, con particolare
attenzione alle biomasse.

La società, dispone di
professionisti tra i più qualificati
sul panorama nazionale, nella
ricerca biomolecolare e biochimica
con specializzazione nella
coltivazione di micro organismi
cellulari adatti alla produzione di
biomassa liquida. Il crescente
interesse dell’industria nella
produzione di biomasse per
produzione di energia elettrica da
fonti rinnovabili, ha spinto
l’azienda ad investire in questo
settore.
Utilizzando le forti competenze dei
propri specialisti, acquisite in
pluriennali esperienze presso centri
di ricerca in Italia, Germania e
Giappone, Ambios ha realizzato una
propria divisione biomedicale,
dotandosi dei necessari strumenti
laboratoristici per tale scopo.
La spiccata vocazione alla ricerca
applicata, è confermata dal progetto
Nasi Elettronici, sviluppato da
Ambios per le esigenze industriali
di olfattometria dinamica; tale
progetto ha portato alla definizione
di una borsa di studio per un anno
per un ingegnere ambientale presso
la struttura di AmbiosSrl.